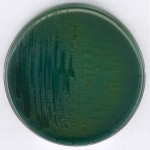
TCBS (Thiosulfate Citrate Bi 500 G

Product Name
GranuCult® prime Thiosulfate Citrate Bile Sucrose (TCBS) Agar, acc. FDA-BAM, ISO 21872
agency
ISO 21872
form
powder
technique(s)
microbiological culture: suitable
pH
8.6±0.2 (25 °C)
application(s)
food and beverages
pharmaceutical
storage temp.
15-25°C
suitability
selective and differential for Vibrio spp.
Quality Level